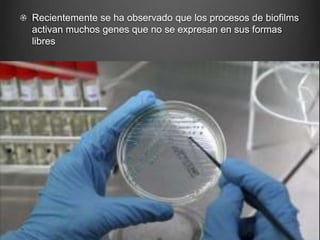
Recientemente se ha observado que los procesos de biofilms
activan muchos genes que no se expresan en sus formas
libres

Este documento describe los conceptos fundamentales de la fisiopatología de las infecciones. En primer lugar, explica cómo los microorganismos pueden causar enfermedades al adherirse a las células del huésped, invadir los tejidos e infiltrar toxinas. Luego, detalla los mecanismos de lesión celular mediados por bacterias, virus y la propia respuesta inmune del huésped. Por último, resume los principales tipos de agentes infecciosos y las defensas del organismo contra las infecciones, incluidas las